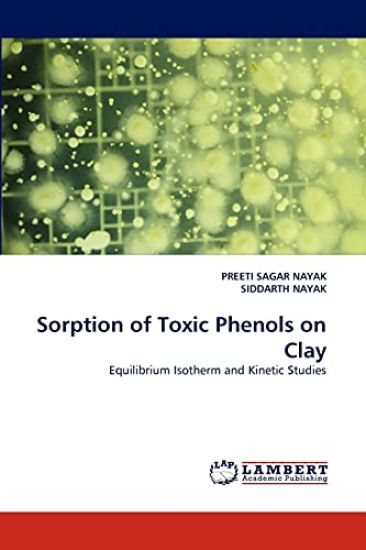
Sorption of Toxic Phenols on Clay

Thunder Rumbles in Preeti's House
Deepak Shimkhada · ISBN 9781490966670
Julkaistu 2013 Kieli englanti nidottu
954 tulosta hakusanalla Preeti S.

Deepak Shimkhada · ISBN 9781490966670
Julkaistu 2013 Kieli englanti nidottu

Preeti Shrivastava · ISBN 9781530204403
Julkaistu 2016 Kieli englanti nidottu

Preeti Sharma; Vasundhara Saxena; Rajeev Gupta · ISBN 9783659468599
Julkaistu 2013 Kieli englanti pokkari
Preeti Sagar Nayak; Siddarth Nayak · ISBN 9783843369381
Julkaistu 2010 Kieli englanti pokkari

Preeti Sharma; Shashi Kanta Varma · ISBN 9783844385878
Julkaistu 2011 Kieli englanti pokkari

Preeti Soni; Swadesin Mahapatra · ISBN 9783846540305
Julkaistu 2011 Kieli englanti nidottu

Preeti Singh; Amlan Kumar Ghosh · ISBN 9786202003124
Julkaistu 2017 Kieli englanti nidottu

Preeti Singh; Atul Jadhav; Neetu · ISBN 9786202855006
Julkaistu 2020 Kieli Ranska nidottu
Chaque dent et chaque mat riau de restauration ont leur propre mod le de contrainte, qu'il est essentiel de reconna tre avant de concevoir une restauration sans risque d' chec....

Preeti Singh; Atul Jadhav; Neetu · ISBN 9786202855013
Julkaistu 2020 Kieli italia nidottu
Ogni dente e ogni materiale da restauro ha un proprio modello di sollecitazione che li riconosce in modo vitale prima di progettare un restauro senza potenziale di fallimento. L...

Preeti Singh; Atul Jadhav; Neetu · ISBN 9786202855037
Julkaistu 2020 Kieli puola nidottu
Każdy ząb i material wypelnieniowy ma sw j wlasny wzorzec naprężeń, rozpoznający je jako niezbędne przed zaprojektowaniem uzupelnienia bez ryzyka uszkodzenia. Budowa odbudowy je...

Preeti Shahi; Nitesh Tiwari; Shekhar Yadav · ISBN 9786203404708
Julkaistu 2021 Kieli puola pokkari
W dzisiejszej dobie wykorzystanie przetwarzania obraz w jest nieinwazyjną procedurą w diagnostyce intencji. Obecnie panuje niezwykly entuzjazm dla możliwości zaprogramowanej tec...

Preeti Shahi; Nitesh Tiwari; Shekhar Yadav · ISBN 9786203472127
Julkaistu 2021 Kieli englanti pokkari
In today's era, the use of image processing is a non-intrusive procedure for diagnostics intention. There is right now an extraordinary enthusiasm for the possibilities of progr...

Preeti Shukla · ISBN 9786204155258
Julkaistu 2021 Kieli espanja nidottu

Preeti Shukla · ISBN 9786204155272
Julkaistu 2021 Kieli Ranska pokkari

Preeti Singh; Amlan Kumar Ghosh · ISBN 9786208201173
Julkaistu 2024 Kieli Ranska pokkari
L'exploitation mini re perturbe consid rablement le paysage et les propri t s du sol, et la remise en tat peut restaurer la qualit du sol au fil du temps. L' valuation des cha...

Preeti Singh; Amlan Kumar Ghosh · ISBN 9786208201180
Julkaistu 2024 Kieli italia pokkari
L'attivit estrattiva provoca drastiche alterazioni del paesaggio e delle propriet del suolo, mentre la bonifica pu ripristinare la qualit del suolo nel tempo. Pertanto, la v...

Preeti Singh; Amlan Kumar Ghosh · ISBN 9786208201258
Julkaistu 2024 Kieli portugali pokkari
A explora o mineira causa perturba es dr sticas na paisagem e nas propriedades do solo, e a recupera o pode restaurar a qualidade do solo ao longo do tempo. Assim, a avalia...

Preeti Singh; Gunjan Singh; Amrish Chandra · ISBN 9789360091729
Julkaistu 2024 Kieli englanti sidottu
"Emerging Approaches in Novel Drug Delivery Systems" explores innovative methods for delivering pharmaceutical substances to targeted areas within the body. Here's an overview:...

Sukhwinder Singh Sran; Preeti Sood · ISBN 9786202673426
Julkaistu 2020 Kieli englanti pokkari
A Virtual Infrastructure Based Dynamic Routing using Mobile Sink technique for Duty Cycled Wireless Sensor Networks is proposed which uses both virtual infrastructure and duty c...